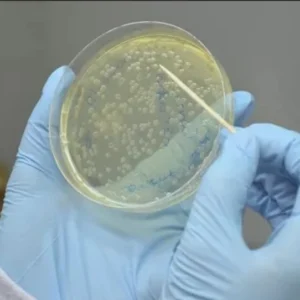
Pesquisa utiliza fungos promotores de energia renovável para agricultura, construções e biocombustíveis fungos

Combustível - resultados da busca
Se você não gostou dos resultados, por favor, faça outra pesquisa
Julho registra menor área queimada em sete anos, mas especialistas alertam para riscos no...
Julho de 2025 trouxe um dado animador para quem acompanha a devastação causada pelo fogo no Brasil. Segundo o Monitor do Fogo, do MapBiomas,...
Biodigestores, a tecnologia que transforma lixo em biofertilizantes e energia limpa
Os biodigestores estão associados a transição energética, combate às mudanças climáticas e a promoção da economia circular
Em um mundo que clama por soluções para as...
Nova ferramenta computacional revoluciona o futuro das usinas de hidrogênio verde no Brasil
O hidrogênio desponta no horizonte energético como uma das mais puras promessas para um futuro sustentável. Sendo o elemento mais comum do universo, seu...
Marina Silva sobre a COP-30 em Belém: “Não podemos destruir a galinha dos ovos...
A menos de 100 dias da Conferência do Clima das Nações Unidas, a COP 30, que será realizada pela primeira vez na Amazônia, a...
Suco de beterraba com laranja aumenta energia e imunidade
Você já se sentiu sem energia logo pela manhã, mesmo depois de uma boa noite de sono? Ou então teve aquela sensação de corpo...
Pro-Amazônia e o equilíbrio de forças financeiras na maior floresta tropical do mundo, crédito...
O dia 5 de agosto de 2025 entrou para o calendário econômico do Brasil como um ensaio de justiça territorial. Na sala restrita da...
Inteligência Artificial lidera corrida por um futuro mais sustentável transformando setores e processos
A Inteligência Artificial molda o futuro da sustentabilidade global
As evidências das alterações climáticas são cada vez mais palpáveis. Ondas de calor extremas, secas prolongadas,...
Quando o sistema solar irá desaparecer?
Depois que o sol se pôr, o que acontecerá com o sistema solar — e quanto tempo isso durará?
Nosso sistema solar existe há 4,6 bilhões de anos ....
Itaipu e Receita Federal transformam contrabando em energia limpa com inovadora usina de biogás
Em uma iniciativa que une criatividade e sustentabilidade, a usina hidrelétrica de Itaipu Binacional, em Foz do Iguaçu, no Paraná, tornou se palco de...
Aeronave híbrida não-tripulada para uso agrícola será criada pela Helisul
O ar sempre foi um vasto palco para a inovação, e agora, mais do que nunca, ele se torna o cenário de uma revolução...
Secas intensas comprometem função hídrica e climática da Amazônia
Há uma ideia recorrente e perigosa de que a floresta amazônica é um organismo autossuficiente, uma espécie de milagre verde que por si só...
Fontes de Energias Renováveis: O Caminho para um Futuro Limpo
Quando pensamos no futuro da humanidade, poucos temas são tão urgentes quanto a transição para fontes de energia renováveis. Em um mundo que ainda...
Carro elétrico emite 2,5 vezes mais CO₂ do que o movido a biometano
Nota técnica publicada pela Empresa de Pesquisa Energética (EPE), vinculada ao Ministério de Minas e Energia (MME), demonstra que o combustível biometano é até...
Amazônia Seca: O Que a Ciência Revela Sobre Esse Fenômeno Extremo
A Amazônia, conhecida mundialmente por sua umidade e por suas chuvas abundantes, enfrenta um dos períodos de seca mais severos de sua história. Rios...
O falso herói da transição: Por que o gnl não é o futuro energético...
Imagine substituir a energia de uma cachoeira por uma fogueira de gás. Parece ilógico, certo? Mas essa é a metáfora mais fiel para o...
O falso herói dos mares: Por que o gnl ameaça os oceanos e o...
Imagine que estamos diante de um transporte marítimo antigo, movida a carvão, e durante décadas ele navegou pelos mares, poluindo o ar e enchendo...
Biomassa pode se tornar a próxima grande força na transição energética brasileira
Apesar de já ser reconhecido mundialmente como um dos países com a matriz energética mais limpa, o Brasil ainda possui um trunfo pouco explorado...
Mistura poderosa: o que adicionar ao açaí para turbinar sua energia e imunidade
Quem já começou o dia com um bom açaí sabe que aquela cor intensa e sabor marcante vão além da estética: o açaí é...
Condições favoráveis para incêndios florestais
Temperaturas mais altas ao redor do mundo estão prolongando as temporadas de incêndios, levando a grandes incêndios florestais. Comparamos as áreas queimadas em três...
Pesquisa utiliza fungos promotores de energia renovável para agricultura, construções e biocombustíveis
Na busca por soluções energéticas mais sustentáveis e economicamente viáveis, cientistas da Universidade Federal de Lavras (UFLA) estão desenvolvendo projetos inéditos que unem biotecnologia,...